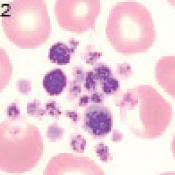
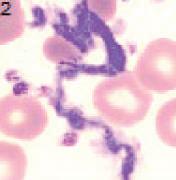
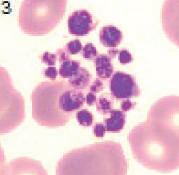

MEDICINA LABORATORIAL
Da Prescrição à Interpretação Clínica





Licenciado em Medicina pela Faculdade de Medicina da Universidade de Lisboa; Internato Complementar de Patologia Clínica no Serviço de Patologia Clínica do Hospital de São José; Grau de Assistente Hospitalar de Patologia Clínica pelo Hospital Curry Cabral, EPE; Especialista em Patolo gia Clínica pela Ordem dos Médicos; Consultor de Patologia Clínica da Carreira Médica Hospitalar no Centro Hospitalar Vila Nova de Gaia/Espinho, EPE – Unidade do Monte da Virgem; Responsá vel pela Coordenação do Controlo da Qualidade Analítica e pela Área Core Laboratorial no Dr. Joa quim Chaves, Laboratório de Análises Clínicas SA; Diretor Técnico Substituto no Dr. Joaquim Chaves, Laboratório de Análises Clínicas SA; esteve envolvido na atividade docente da cadeira de Farmacologia da Faculdade de Medicina da Universidade de Lisboa; foi convidado para fazer parte de vários grupos de trabalho.
A todos aqueles que foram, e muitos continuam a ser, os meus mestres, colegas e amigos, e que me têm acompanhado e acrescentado valor à minha formação pessoal, académica e profissional, em particular ao Dr. Joaquim Chaves pela confiança que sempre depositou em mim, pela sua amizade e por todas as oportunidades que me concedeu.
À Senhora Dra. Maria José Rodrigues, responsável do laboratório de referência de Imuno ‑Hematologia do Centro de Sangue e da Transplantação de Lisboa, pela amizade demonstrada há mais de 10 anos e pela generosidade com que se disponibilizou para rever, corrigir e melhorar o conteúdo científico da Imuno‑Hematologia.
Conheço o Dr. Rui Pimentel há mais de 40 anos, desde que nos cruzámos no Internato de Patologia Clínica no Hospital de São José.
A sua dedicação à Medicina, consubstanciada na Patologia Clínica, foi sempre muito grande e pro porcionou, ao longo dos anos, a necessidade de aprofundar conhecimentos e de os transmitir, confor me agora evidenciam os cinco volumes de Medicina Laboratorial.
Trata se da compilação de um exaustivo trabalho de pesquisa, de estudo e de prática laboratorial, de grande utilidade para os cursos e aulas ministrados.
Os volumes da obra Medicina Laboratorial são, antes de mais, uma seleção de matéria e sistematiza ção de conhecimentos que interessam à área da Medicina Laboratorial, nesta sua vertente, e aos quais não era possível aceder senão pela consulta de extensa bibliografia, a qual se encontra, ao longo dos capítulos, também aqui disponível.
Em relação à Hematologia, estão contempladas, entre outras:
• A Hematologia geral, destacando-se o hemograma [haîma (sangue), grámma (registo)]. Conta gem e caracterização dos elementos figurados do sangue periférico e a importância desta análise no despiste da doença hematológica;
• A morfologia de sangue periférico, com especial destaque para as hemoparasitoses;
• O estudo das anemias;
• A hemóstase, com relevo especial para a trombofilia e fibrinólise.
Congratulo me com publicação desta obra, que vai preencher uma grande lacuna no acesso ao conhecimento desta área, e vai permitir ao público alvo aceder ao conhecimento detalhado e um melhor estudo da Hematologia.
Margarida Silveira
Ex Diretora do Serviço de Patologia Clínica do Instituto Português de Oncologia de Lisboa Francisco Gentil, EPE
O presente trabalho é, essencialmente, uma compilação modulada de boas práticas no âmbito da prescrição médica, de todas as fases do processo laboratorial (pré‑analítico, analítico e pós‑analítico) e da interpretação dos resultados analíticos. Baseia‑se na minha experiência clínica e laboratorial, que foi sendo adquirida e amadurecida ao longo de mais de quatro décadas, mais de metade das quais na Dr. Joaquim Chaves, Laboratório de Análises Clínicas, e nas evidências publicadas na literatura cientí fica das diversas especialidades médicas.
Aceitei o desafio proposto pelas minhas colegas e amigas, Catarina Rombo, Marina Pires e Rute Pereira, e pela minha mulher, Margarida Ponte, de publicar Medicina Laboratorial: Da prescrição à interpretação clínica por estar convencido de que a partilha, em todas as áreas do conhecimento, nas quais se inclui a Medicina Laboratorial, é uma janela de oportunidade imperdível, por permitir criar as condições necessárias para explicar a importância da relação entre a clínica e o laboratório, em que o diálogo entre pares deve ser permanente, assim como o significado de muitos sinais do âmbito da Patologia Clínica. Estou convicto de que esta obra constitui um importante contributo para melhorar a compreensão e o processo de interpretação dos resultados dos parâmetros laboratoriais (mesurandos) prescritos, uma vez que é neles que se baseiam entre 60 e 70% das decisões médicas, que condicionam a qualidade de vida das pessoas e, muitas vezes, o seu tempo de sobrevida.
Revisitada a literatura médica publicada, quer em livros de texto, quer em artigos científicos nacionais e internacionais, é evidente a existência de uma enorme lacuna, que se traduz na insufici ência de articulação, cooperação e coordenação de esforços interdisciplinares. Está patente, também, um afastamento cada vez maior entre o que é pretendido e tomado como necessidade por cada uma das especialidades médicas e cirúrgicas e as limitações e potencialidades do estado da arte da Medicina Laboratorial, que importa conhecer e colmatar.
Só há uma Medicina. A Medicina como a Arte Maior de ajudar as pessoas a terem a melhor quali dade de vida (bem‑estar físico, psíquico e social) durante o máximo tempo possível.
No âmbito da Hematologia, Medicina Laboratorial faz uma abordagem prévia aos processos de validação e de interpretação dos resultados laboratoriais e abrange três grandes grupos temáticos da Hematologia geral, designadamente o hemograma, o estudo morfológico do sangue periférico (EMSP) e a classificação e diagnóstico das anemias. São ainda abordadas as hemoparasitoses, a imuno ‑hematologia, no contexto da Patologia Clínica, e a hemóstase, trombofilia e fibrinólise. Embora sejam complementares e estejam diretamente correlacionados, pela sua especificidade e extensão, a hemato ‑oncologia e o mielograma serão objeto de outra publicação.
Neste trabalho, são caracterizados, ao longo dos diferentes capítulos, os parâmetros laboratoriais (mesurandos) com maior valor semiológico no âmbito do rastreio, do diagnóstico, da monitorização da evolução clínica e resposta ao tratamento, e da estratificação do risco (prognóstico) das diferentes entidades nosológicas, assim como a sua sensibilidade e especificidade, tendo em consideração o esta do da arte atual.
Os médicos recorrem às análises clínicas quer para efetuar diagnósticos, estratificar o risco de morbilidade e de mortalidade, identificar recaídas ou recorrências e monitorizar a evolução clínica e a resposta ao tratamento de diversas entidades nosológicas, quer para despistar a presença destas entida des em indivíduos aparentemente saudáveis.
A principal responsabilidade da Medicina Laboratorial é contribuir para melhorar de forma consis tente a qualidade de vida das pessoas (estado de completo bem‑estar físico, psíquico e social) durante o máximo tempo possível, devendo, para isso, garantir que, de forma sustentada, todos os resultados reportados se caracterizem pelos seguintes aspetos:
• Não estejam comprometidos por enviesamentos inaceitáveis em relação ao valor real (in vivo);
• Sejam clinicamente úteis para permitir a tomada de decisões médicas mais adequadas;
• Sejam reportados em tempo útil.
Tem sido evidenciado que até 25% dos erros de avaliação clínica relacionados com os resultados laboratoriais afetam o processo de decisão médica, tendo como consequência atrasos na prestação dos cuidados de saúde mais adequados em tempo útil (Lippi, G. et al., 2008).
A caracterização da variabilidade fisiológica, fisiopatológica e iatrogénica, e a identificação e moni torização da variabilidade que decorre do processo analítico, assim como a garantia de que se mantém dentro de limites clinicamente aceitáveis, são fundamentais para que as informações veiculadas pelos resultados reportados não induzam os clínicos prescritores a cometer erros de julgamento em relação a um diagnóstico, prognóstico (estratificação do risco) ou tratamento e, assim, diminuindo a qualidade de vida dos pacientes.
A variabilidade dos resultados laboratoriais está relacionada com diversos fatores e condições, dos quais se destacam, de acordo com a sua origem, os seguintes:
• A variabilidade biológica intraindividual específica de cada mesurando (equilíbrio homeostático);
• As alterações do estado de saúde dos indivíduos (variabilidade fisiopatológica);
• As alterações decorrentes de atos ou de intervenções no âmbito da terapêutica ou do diagnóstico (variabilidades iatrogénicas);
• O processo pré‑analítico, analítico e pós‑analítico, designadamente a competência dos profissio nais envolvidos (fatores humanos) e a qualidade do desempenho dos diferentes procedimentos de medida e ensaios instalados no laboratório (exemplos: precisão e exatidão próprias do método, intervalo de medição e linearidade, limites de deteção e especificidade analítica);
• A estabilidade dos mesurandos (analitos e parâmetros) nas amostras biológicas em função das suas características, da preparação pré‑analítica efetuada e das condições de colheita, de conserva ção e do seu processamento;
• As interferências analíticas positivas ou negativas que se traduzem pela diferença entre o resultado obtido e o seu valor real (in vivo).
Antes de ser tomada uma decisão perante resultados laboratoriais anormais ou discordantes, seja através da história clínica, epidemiológica ou ambas, seja com recurso a critérios interparamétricos, ou ainda através dos resultados obtidos em colheitas anteriores, é importante que o processo de interpre tação, tanto a nível laboratorial como clínico, permita determinar se estes resultados estão relacionados
XVI Medicina Laboratorial: Hematologia
com o estado de saúde dos pacientes ou se são resultantes de variáveis pré‑analíticas, analíticas ou pós ‑analíticas, nas quais se incluem as interferências.
O impacto negativo que os resultados incorretos podem ter para os pacientes está relacionado com os seguintes fatores:
• Estado de saúde e características das patologias que o condicionam;
• Sensibilidade e especificidade diagnósticas (valor semiológico) dos mesurandos objeto de análise;
• Grandeza da diferença entre o resultado reportado e o seu valor real (in vivo);
• Competência e experiência, quer dos profissionais do laboratório, quer dos médicos prescritores, em identificar e lidar com este tipo de resultados, visando minimizar a gravidade do dano.
A hematopoiese fisiológica é um processo con tínuo que ocorre na medula óssea (BM – bone marrow) e que tem a capacidade de produzir um elevado número de células sanguíneas, visando manter a homeostasia através da substituição efi caz (renovação) dos elementos figurados maduros [BM e sangue periférico (SP)], que vão sendo des truídos rapidamente em virtude de terem um tem po de vida médio (T ½) curto. No adulto, a taxa de renovação dos elementos figurados maduros (mieloides, eritroides e plaquetas) é de cerca de 1,5x106 células hematopoiéticas por segundo.
As células sanguíneas são formadas em vagas distintas durante a embriogénese. O saco vitelino (yolk sac) produz os progenitores eritroides pri mitivos, seguidos pelos progenitores eritromie loides, enquanto as células da região embrionária aorta‑gónadas‑mesonefros (AGM – aorta‑gonad ‑mesonephros) são a primeira fonte das células es taminais hematopoiéticas (HSC – hematopoietic stem cells), que, subsequentemente, vão colonizar o fígado fetal e a sua BM.
As HSC localizam‑se predominantemente na BM e ocupam o topo da cascata hierarquizada de diferenciação do sistema hematopoiético. Es tas células são relativamente escassas (cerca de 0,01% da celularidade total), têm um T ½ muito longo e, intrinsecamente, possuem uma capaci dade ilimitada de autorrenovação e de amplifica ção (divisão celular simétrica), permitindo que seja assegurada a sua preservação a longo prazo, evitando a exaustão (depleção total), assim como de proliferação (expansão) e diferenciação em todos os tipos de células hematopoiéticas multi linha (divisão celular assimétrica).
As HSC constituem a reserva celular respon sável pela manutenção da hematopoiese e têm a capacidade de responder rapidamente às ne cessidades do organismo em situações de stress (exemplos: molecular oxidativo ou de outra na
tureza, nomeadamente traumática, cardíaca ou resultante de atividade física intensa) ou de do ença. A diferenciação das HSC em células pro genitoras multipotentes (MPP – multipotent pro genitor) acompanha‑se pela perda da sua capaci dade de autorrenovação. As MPP diferenciam‑se subsequentemente em 2 tipos de células com potencial de linhagem e velocidade de prolife ração diferentes: nas progenitoras mieloides co muns (CMP – common myeloid progenitor) e nas progenitoras linfoides comuns (CLP – common lymphoid progenitor).
As características imunofenotípicas mais im portantes dos elementos celulares do sistema he matopoiético são:
• HSC: cluster de diferenciação, molécula 34 (CD34+), 133 (CD133+), 90 (CD90+) e, algu mas, com expressão 117 (CD117+), e cluster de diferenciação, molécula 45, epítopo RA ausente (CD45RA );
• MPP: CD38dim/ , CD117+, CD34+, CD59+, ausência de expressão cluster de diferencia ção, molécula 90 (CD90 ) e CD45RA ;
• Células progenitoras linfoides: CD38+, CD34+, expressão fraca da interleukin‑3 receptor alpha chain (IL3Rαdim), CD117 e CD45RA :
– Células T: CD7+, CD2+, CD3+, CD4+ (hel per) e CD8+ (citotóxicas);
– Células B: CD19+, CD22+ e CD72+;
– Células NK: CD56+ e CD16+.
• Células progenitoras mieloides: CD38+, CD34+, CD117+, CD123+, CD13+ e CD33+:
– Células dendríticas: CD11c+ e CD209+;
– Macrófagos: CD14+ e CD33+;
– Células eritroides: CD235a+ [glicoforina A (GPA)], CD36+, CD71+ (recetor da TRF) e CD105+;
– Granulócitos: CD13+, CD33+ e CD15+;
– Monócitos: CD64+, CD11c+ e CD14+;
– Megacariócitos (MK)/Plaquetas: CD41a (glicoproteína IIb/IIIa), CD41 (glicopro

e das plaquetas, quer para o EMSP a partir de es fregaços corados pelos corantes de Romanowsky, nos quais se inclui a coloração de MGG.
d) Índices plaquetários:
• VPM (volume plaquetário médio = plaque tócrito ÷ n.º de plaquetas):
– Valores baixos estão associados a trombo citopenias de origem medular (central);
– Situações em que os seus valores estão ele vados:
■ Doentes com trombocitopenias por des truição periférica (macrotrombocitope nias);
■ Sangue anticoagulado com EDTA a par tir dos 30 minutos, atingindo o seu valor máximo entre as 6 e as 24h (±13,4%); a partir das 24h, o seu número começa a diminuir por fragmentação das plaquetas.
• Índice de anisocitose plaquetára (PDW): é um marcador de ativação plaquetária; os seus valores estão elevados nos doentes com trombocitopenias por aumento da destrui ção periférica e nas patologias hematoló gicas que se acompanham por anisocitose plaquetária;
• P‑LCR: reflete o número de plaquetas com volume > 12 fL dividido pelo seu n.º total; os seus valores estão elevados nos doentes com trombocitopenias por destruição peri férica e nas patologias hematológicas que

se acompanham pela presença de plaquetas gigantes.
e) Determinação da fração de plaquetas ima turas (IPF%):
• Sempre que este parâmetro estiver dispo nível, deve ser determinado e reportados os seus resultados (valor percentual e absoluto) sempre que os valores das plaquetas forem < 100x109/L e não se identifique a presença de agregados plaquetários (contraindica a sua execução);
• A IFP% traduz o valor das plaquetas reticu ladas (recém‑formadas ricas em ARN resi dual e com VPM elevado), reflete a atividade trombocitopoiética medular (IPF% elevada versus baixa) e permite classificar as trombo citopenias em 2 grandes grupos:
– Hiperproliferativas (IFP > 9,0%), por aumento da destruição periférica:
■ Baixo risco de hemorragia (exemplos): púrpura trombocitopénica idiopática, TTP e hiperesplenismo;
■ Aumento dos seus valores entre 1 e 5 dias antes dos valores da concentração das plaquetas, após a transplantação de HSC.
– Hipoproliferativas (IFP ≤ 9,0%) por insu ficiência medular:
■ Elevado risco de hemorragia (exem plos): aplasia ou hipoplasia medular, ou displasia dos MK.
A anemia contribui para o aumento da mor bilidade e da mortalidade, para a diminuição da qualidade de vida, do desempenho e da produ tividade no trabalho, tal como para o atraso ou disfunção do desenvolvimento neurológico, cog nitivo e comportamental.
A anemia é definida como uma concentração de Hb inferior ao limite do intervalo de referên cia para o sexo, grupo etário e altitude da resi dência habitual em relação ao nível médio das águas do mar.
A concentração da Hb reflete a capacidade potencial de transporte de oxigénio e o estado de oxigenação tecidular.
A anemia não é um diagnóstico. É uma mani festação de uma patologia subjacente. No estado de anemia, a concentração da Hb é insuficiente para transportar a quantidade de oxigénio re querido para suprir as necessidades das células e tecidos do organismo.
A prevalência da anemia a nível global, em 2010, era de 32,9%, sendo a ferropenia a etiolo gia mais frequente; as anemias macrocíticas têm uma prevalência entre 2 e 4%.
Ao nível do mar e até aos 999 metros de alti tude, a OMS define anemia quando a concen tração da Hb (g/dL):
• Nos RN, é < 14,0;
• Nas crianças entre os 6 meses e os 4 anos de idade, é < 11,0;
• Nas crianças entre os 5 e os 11 anos de idade, é < 11,5;
• Nas crianças entre os 12 e os 14 anos de ida de, e nas mulheres não grávidas a partir dos 15 anos, é < 12,0;
• Nas mulheres grávidas:
– 1.º trimestre é < 11,0;
– 2.º e 3.º trimestres é < 10,5.
• Nas primeiras 6 semanas após o parto, é < 10,0;
• No sexo masculino, a partir dos 15 anos, é < 13,0.
Para a OMS, a anemia é considerada grave quando os valores da Hb g/dL são < 7,0 nas crian ças entre os 6 e os 59 meses de idade e nas mulhe res grávidas, e < 8,0 nos restantes indivíduos.
A partir dos 1000 metros inclusive, a cada um dos valores da Hb referidos nos parágrafos ante riores deve ser acrescido o da concentração cor respondente à altitude constante na Tabela 4.1.
Tabela 4.1 • Valor médio do acréscimo de Hb (g/dL) em relação à altitude (≥ 1000 metros do nível médio da água do mar).
1.1. aNemias agudas
Depois da instalação do estado de anemia –que, se não for compensada, ocorre a partir do 2.º dia do início do episódio de hemorragia ou de hemólise agudas –, os doentes podem apresen tar precocemente, em função da sua gravidade, as seguintes manifestações clínicas: palidez da pele e das mucosas (conjuntivas oculares, cavi dade oral e faringe, linhas das palmas das mãos e base das unhas), dispneia de esforço, polipneia,

Figura 11.2 • (WHO – “Basic malaria microscopy Part 1, 2ed., 2010). Diferentes aspetos morfológicos dos esquizontes no esfregaço fino (linha superior) e na gota espessa (linha inferior).
• Gametócitos: aspetos morfológicos impor tantes para a identificação da espécie: tama nho, forma, e aspeto do gametócito; tama nho, forma, relação N:C e distribuição da cromatina nuclear (macrogametócitos femi ninos ‑ compacta; microgametócitos mas culinos ‑ cromatina mais difusa); cor, quan tidade, aspeto e distribuição do pigmento malárico. (Figura 11.3);

Figura 11.3 • (WHO ‑ “Basic malaria microscopy Part 1, 2ed., 2010). Diferentes aspetos morfológicos dos gametócitos no esfregaço fino (linha superior) e na gota espessa (linha inferior).
• Pigmento malárico ou hemozoína:
– Material granular fino a grosseiro, disper so ou agregado, ou massa única, castanho ‑amarelado, castanho‑escuro ou preto, que constitui o produto do catabolismo da Hb eritrocitária metabolizada pelos Plasmo dium spp;
– Está presente no citoplasma dos trofozoí tos maduros, dos esquizontes e dos game tócitos;
– Pode ser identificado como material fago citado no citoplasma dos neutrófilos, dos monócitos e dos macrófagos; o valor per centual dos elementos figurados que o evi denciam, sobretudo dos neutrófilos, é um importante marcador de prognóstico.
1.4.5. Chave para a identificação morfológica das espécies de Plasmodium
1.4.5.1 Gota espessa
1.4.5.1.1. Plasmodium falciparum
Na infeção pelo Plasmodium falciparum a for ma de apresentação mais frequente caracteriza ‑se pela presença de trofozoitos, de gametócitos ou de ambos. A presença de esquizontes associa dos às formas anteriores, em particular aos trofo zoítos é rara e é sinal de mau prognóstico:
• Trofozoítos: habitualmente numerosos, de tamanho pequeno a médio, com citoplas ma homogéneo em forma de vírgula ou crescente, alguns em anel, com presença de muitas formas com dois pontos de croma tina (núcleos redondos, alongados ou com formas irregulares). Os trofozoítos maduros apresentam citoplasma compacto com grâ nulos grosseiros escassos ou massa única de pigmento malárico (Figura 11.4);


ma dos indivíduos, cuja produção não foi induzida por antigénios eritrocitários, mas que reagem com as células e/ou com molé culas presentes nos reagentes. A produção deste tipo de anticorpos pode ser induzida por diversas substâncias químicas (exem plos: EDTA e citrato) e por agentes anti microbianos (exemplos: β‑lactâmicos, clo ranfenicol, aminoglicosidos, tetraciclinas e vancomicina).
a) Mecanismos e características da reatividade dos eritrócitos:
• Formam complexos de antigénio‑anticorpo, cuja reação indicadora na mistura reativa se traduz por aglutinação e/ou hemólise dos eritrócitos;
• Os anticorpos podem ligar‑se aos antigénios presentes na superfície dos eritrócitos;
• A aglutinação dos eritrócitos pode ser estimu lada e amplificada pela presença de moléculas exógenas, que não estão diretamente relacio nadas com a reação antigénio‑anticorpo.
b) Existem diversos tipos de anticorpos com es pecificidade para várias substâncias químicas, nas quais se incluem os fármacos, que inter ferem com os ensaios, cuja ligação aos eritró citos pode ser covalente ou não covalente. Ao contrário do que se passa com as ligações co valentes, que não são facilmente removíveis, a reatividade residual do soro ou do plasma e a que se deve aos anticorpos interferentes, cuja ligação aos eritrócitos se faz predominante mente de forma não covalente, podem ser removidas através da lavagem adequada dos eritrócitos. Estes anticorpos podem apresen tar especificidade para determinantes antigé nicas de sistemas de grupo sanguíneo.
Tabela 15.1• Comportamento serológico e importância clínica dos anticorpos.
Origens Associações
Sistemas de grupo sanguíneo
AB0 –
Imunes (Aloanticorpos ou irregulares: naturais ou após transfusão ou gravidez)
Hiperimune
Anti‑A e Anti ‑B são IgG e reagem a 37ºC: pós‑transfusão ou gravidez
HDFN (Grávida)
Reações hemolíticas transfusionais
Observações Nativos (naturais)
– –
• Até aos 3 a 6 meses de idade, os anticorpos têm fraca atividade ou são inexistentes; • O título equivalente ao dos adultos é atingido entre os 5 e os 10 anos de idade
Anti‑A Sim (IgM) Sim Sim Sim Hemólise
Anti‑B Sim (IgM) Sim Sim Sim Hemólise
Anti‑AB Sim (IgM) Sim Sim Sim Hemólise
Anti‑A1 Sim (IgM) Raro Não Sim
2% dos A2 e 25% dos A2B
Esta coleção de 5 volumes apresenta as fases da prescrição médica, do processo laboratorial (pré-analítico, analítico e pós-analítico) e da interpretação dos resultados analíticos. É explicada e evidenciada a importância da relação entre a clínica e o laboratório, cujo diálogo entre pares deve ser permanente, e clarificado o significado de muitos sinais do âmbito da Patologia Clínica, que são representados e se traduzem nas diferentes formas como os resultados dos parâmetros laboratoriais prescritos podem ser reportados e devem ser interpretados.
Destina-se a internos e especialistas em Patologia Clínica; estudantes de Medicina; médicos de diversas especialidades que, na prática clínica diária, prescrevem análises clínicas e interpretam os seus resultados; estudantes e profissionais das áreas de Ciências Farmacêuticas, Ciências Biomédicas, Biologia e Bioquímica em formação e especialistas em Análises Clínicas; interessa também a técnicos de análises clínicas e saúde pública.
Hematologia
Neste livro, , são abordados os aspetos mais importantes da Hematologia geral, designadamente do hemograma, do estudo morfológico do sangue periférico, da classificação e diagnóstico das anemias e das hemoglobinopatias, assim como das hemoparasitoses, da imuno-hematologia e da hemóstase, trombofilia e fibrinólise. São caracterizados, ao longo dos diferentes capítulos, os parâmetros laboratoriais (mesurandos) com maior valor semiológico no âmbito do rastreio, do diagnóstico, da monitorização da evolução clínica e da resposta ao tratamento, e da estratificação do risco (prognóstico) das diferentes entidades nosológicas, assim como a sua sensibilidade e especificidade.

